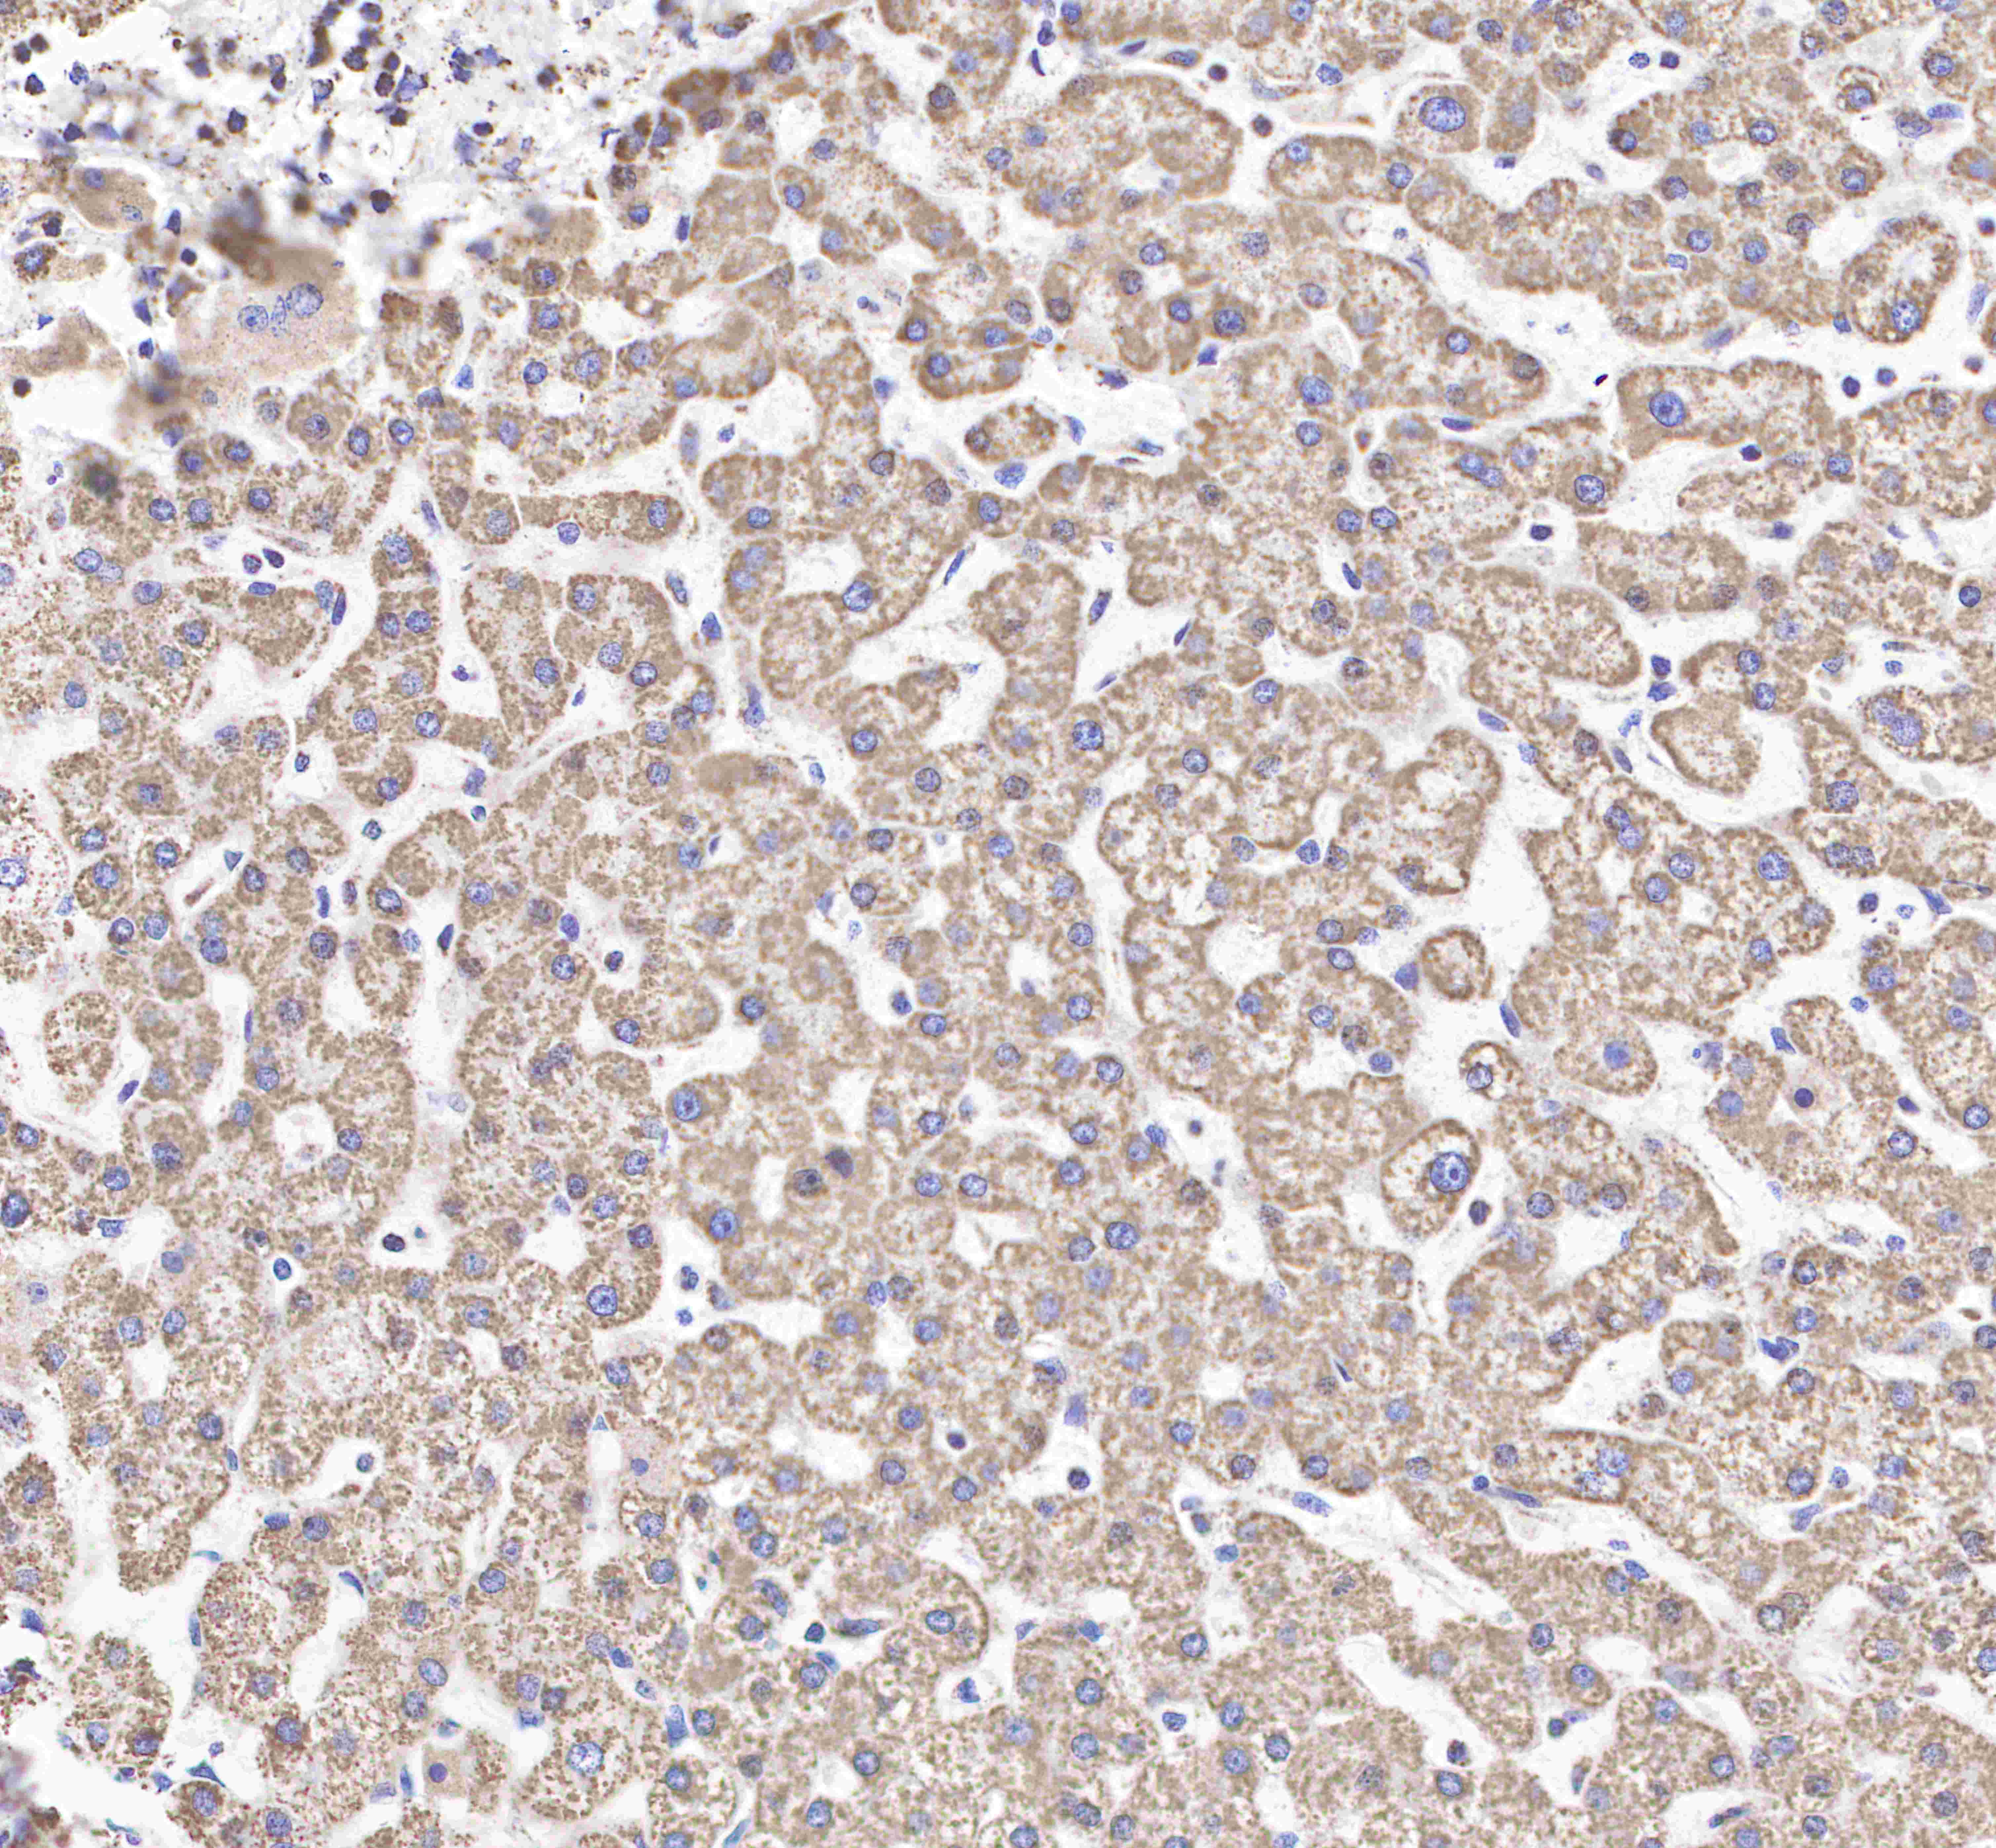
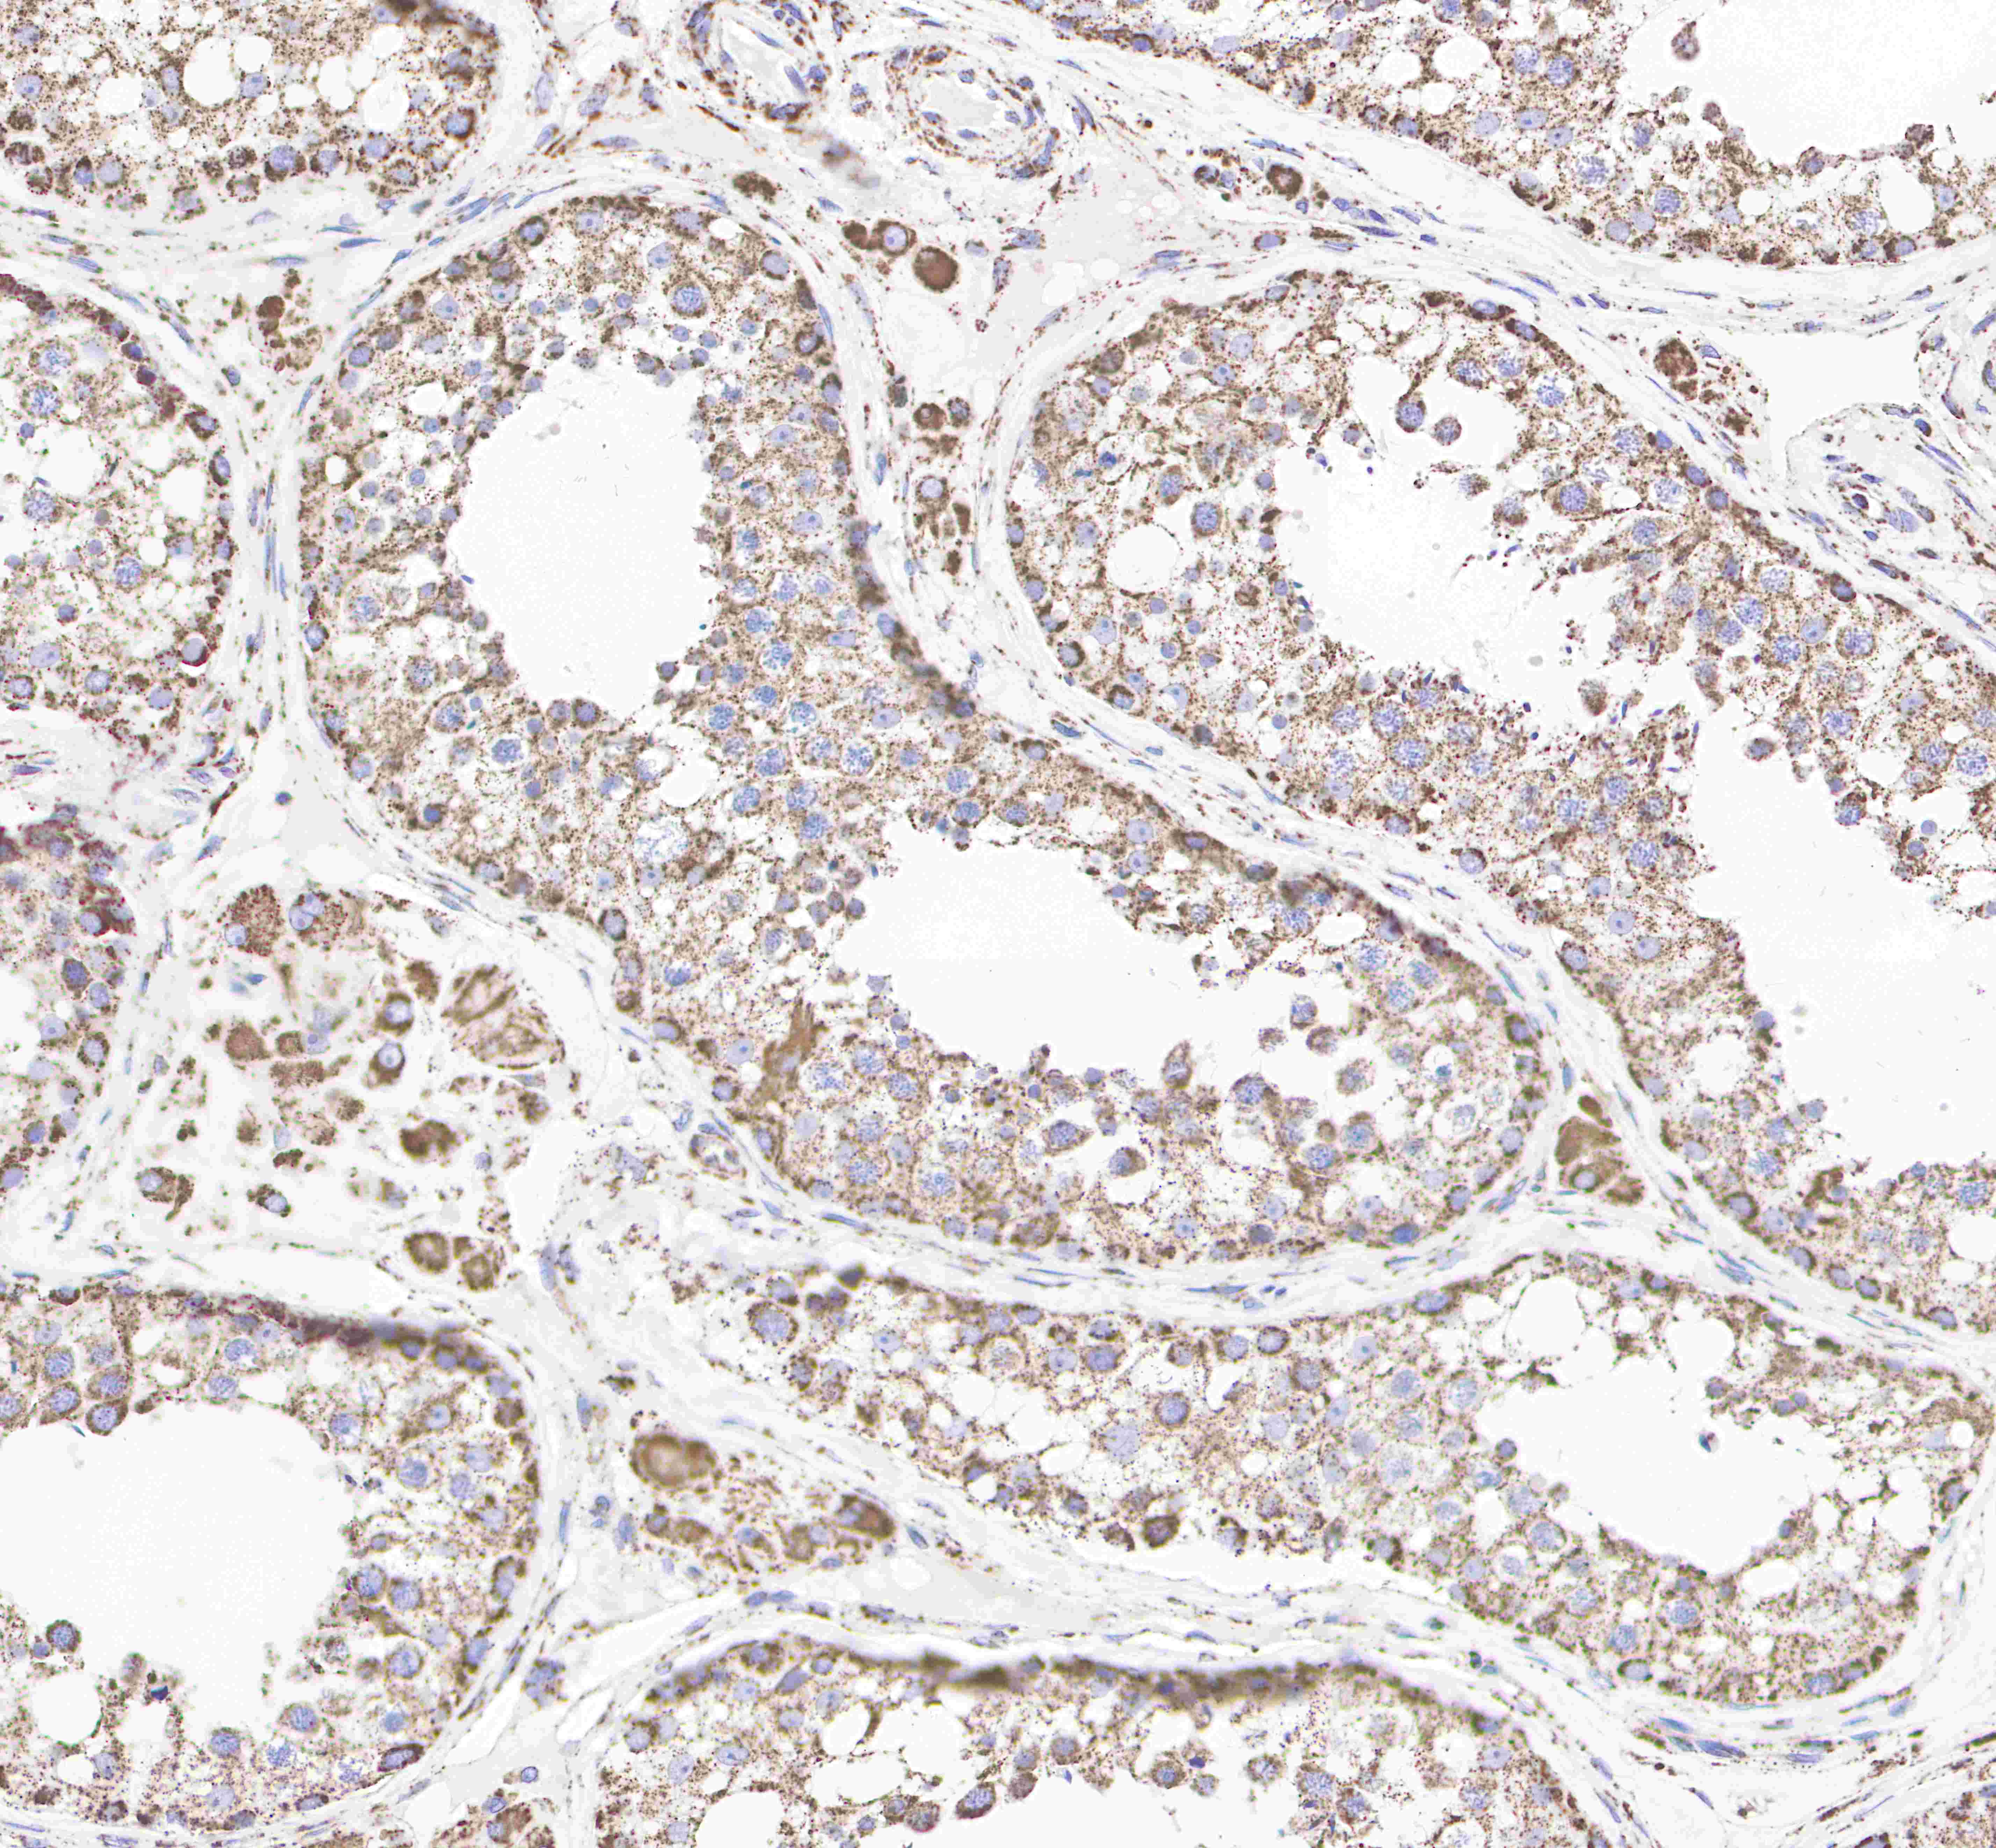
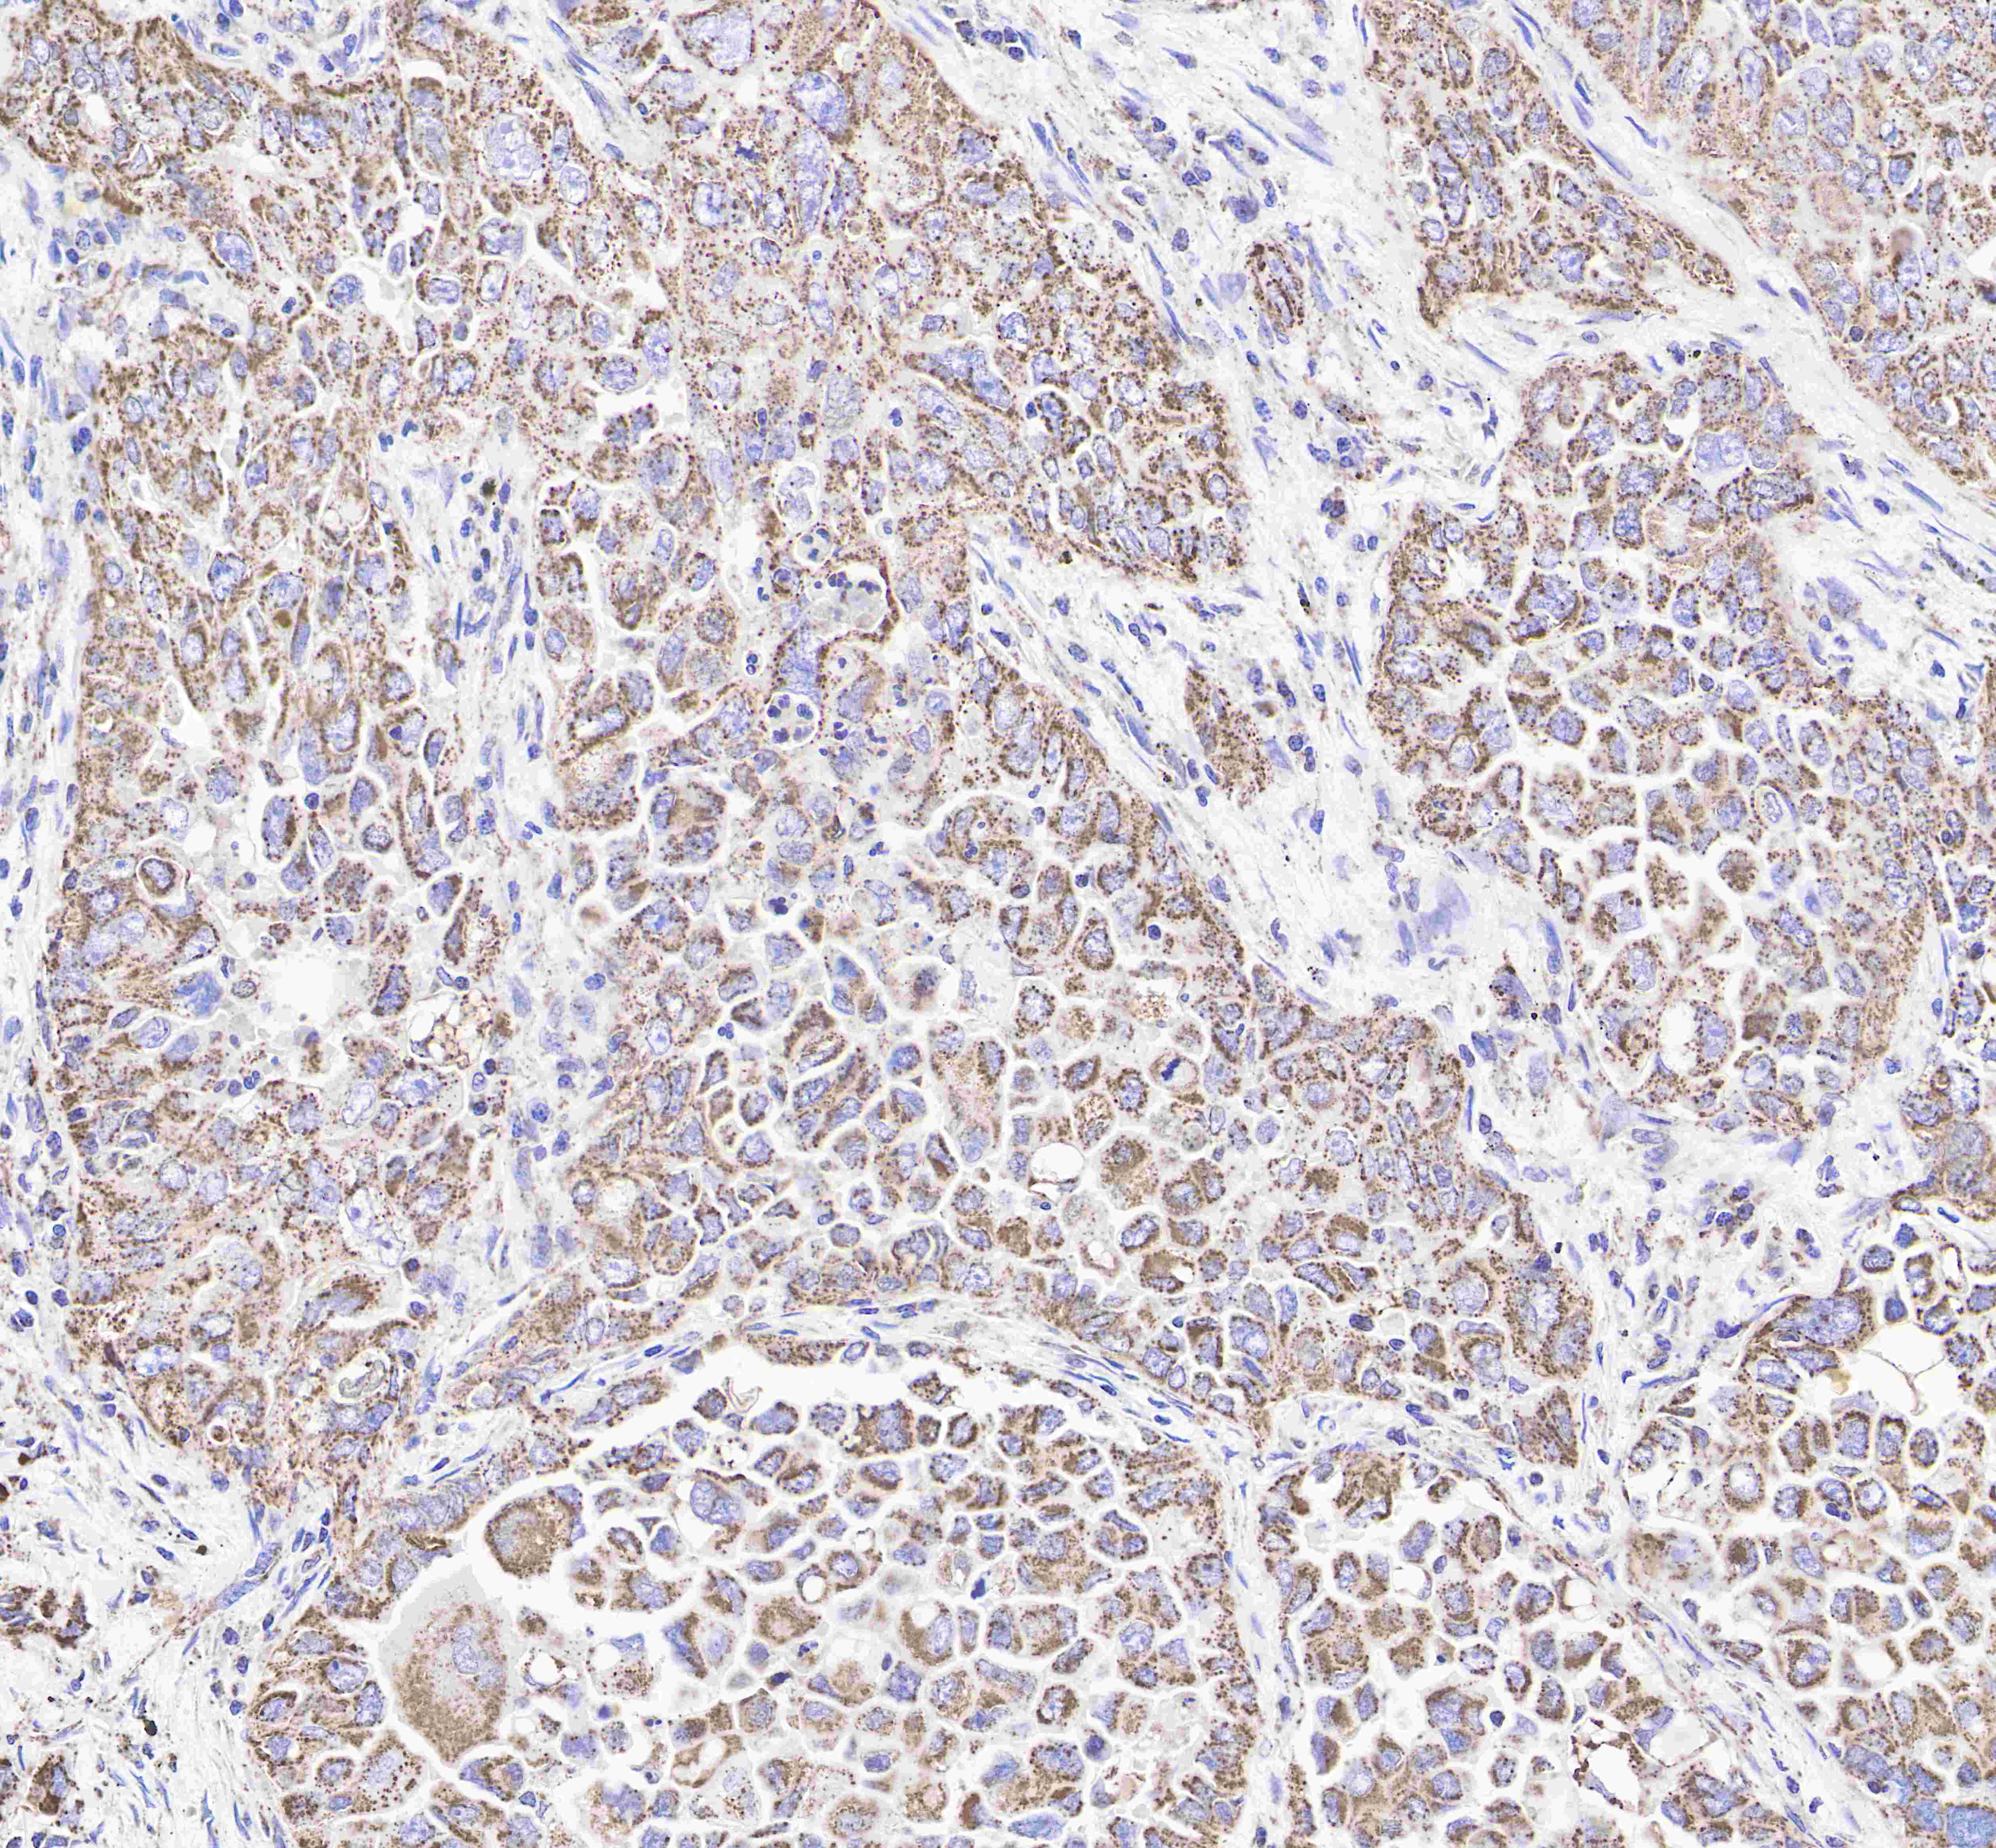

Product Specification
| Host |
Rabbit |
| Antigen |
HSP60 |
| Synonyms |
60 kDa chaperonin; Chaperonin 60 (CPN60); HuCHA60; Mitochondrial matrix protein P1; P60 lymphocyte protein |
| Immunogen |
Recombinant Protein |
| Location |
Intracellular |
| Accession |
P10809 |
| Clone Number |
SDT-R012 |
| Antibody Type |
Rabbit mAb |
| Application |
WB, IHC-P, ICC, ICFCM |
| Reactivity |
Hu, Ms, Rt |
| Purification |
Protein A |
| Concentration |
0.5mg/ml |
| Molecular Weight |
60kDa |
| Conjugation |
Unconjugated |
| Physical Appearance |
Liquid |
| Storage Buffer |
PBS, 40% Glycerol, 0.05%BSA, 0.03% Proclin 300 |
| Stability & Storage |
12 months from date of receipt / reconstitution, -20 °C as supplied. |
Dilution
| application |
dilution |
species |
| ICC |
1:500 |
|
| IHC-P |
1:500 |
|
| ICFCM |
1:500 |
|
| WB |
1:1000-1:20000 |
|
Background
HSP60, also known as chaperonins (Cpn), is a family of heat shock proteins originally sorted by their 60kDa molecular mass. They prevent misfolding of proteins during stressful situations such as high heat, by assisting protein folding. HSP60 belongs to a large class of molecules that assist protein folding, called molecular chaperones.